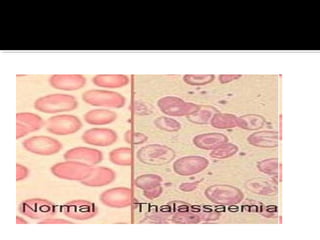

Dokumen tersebut membahas tentang genetika, yang mempelajari penurunan sifat dari induk ke keturunan. Beberapa konsep kunci yang dijelaskan adalah gen, kromosom, homozigot, heterozigot, dan berbagai jenis persilangan seperti monohibrid, dihibrid, dan trihibrid. Dokumen ini juga membahas beberapa penyakit menurun pada manusia seperti hemofilia dan buta warna.